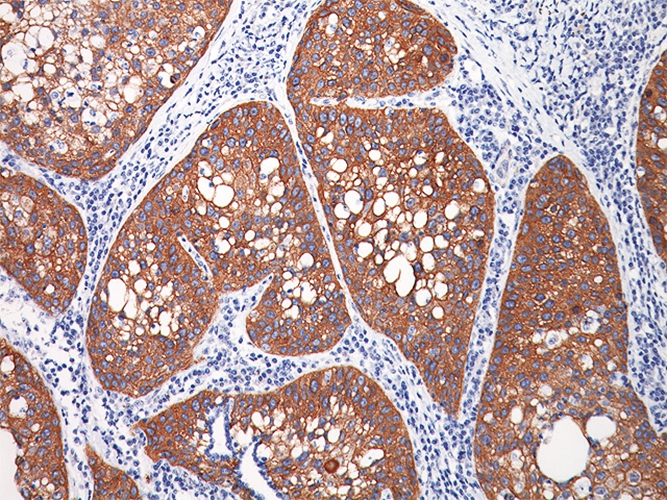
高分化肺腺癌切片

肺腺癌圖片

左肺腺癌術後胸腔內

中分化肺腺癌

轉移性肺腺癌怎麼治療

右上肺腺癌

右下肺腺癌 的

有效治療肺腺癌患者

晚期肺腺癌患者左鎖骨轉移

吸菸肺腺癌症狀

小細胞型肺腺癌

一位早期肺腺癌患者的手術

浸潤性肺腺癌早期症狀

老人肺腺癌腹水腳腫

女性肺腺癌患者的臨床症狀

腎腫瘤轉移肺腺癌症狀

晚期肺腺癌患者的手象

高分化肺腺癌鏡下
高分化肺腺癌切片

肺腺癌腫瘤

肺腺癌左肺全切

肺腺癌胸椎轉移瘤
肺腺癌相關文章
肺腺癌相關問答
A:肺腺癌病人晚期吃靶向藥,一般的存活期可能是2-3年,也可能是3-5年的時間。有些肺腺癌晚期的病人吃靶向藥之後療效會比較好,可能存活7-8年的時間,甚至是存活更長的時間。還有些肺腺癌晚期的病人吃靶向藥物效果並不好,生存期可能會縮短到一年左右的……
A:肺腺癌是非小細胞肺癌當中常見的病理類型,近年來肺腺癌在我國的發生率在逐年的上升。從病理學的角度上來看,肺腺癌屬於起源於支氣管腺體的一種惡性腫瘤。肺腺癌可以發生在各級支氣管,以發生在小支氣管為多見。如果是周圍型肺腺癌,臨床症狀在早期的時候並……
A:並不能說肺腺癌哪裡轉移最可怕,關鍵的是看肺腺癌轉移到不同的部位之後,是不是引起了各組織器官功能的異常,從而導致病人出現痛苦,說明如下:1、肺內的轉移、肝轉移、腦轉移,甚至骨轉移:都是對病人的生命會造成不良影響的情況,可以給病人帶來不同程度……
A:肺腺癌最有效的中藥這種說法不科學,中醫藥辨證治療疾病一般來說是要根據患者的症狀、結合他的舌,來進行辨證論治,常見如下:1、清金化痰湯加減:肺腺癌的患者如果出現了咳嗽、咳黃膿痰,或者是咳膿血痰,伴有胸高脅脹、胸痛、小便黃、大便幹、舌紅苔黃膩……
A:肺腺癌是很嚴重的惡性腫瘤,肺腺癌的病人如果能夠早發現、早診斷、早治療,大部分病人通過根治性手術切除,一般可以治癒。肺腺癌中期的病人手術治療的同時,需要配合化療、放療、靶向藥物治療來控制病情,防止復發,中期的肺腺癌病人五年生存率可達60%左右……
A:肺腺癌是很嚴重的惡性腫瘤,早期的肺腺癌病人如果能夠早發現、早診斷、早治療,大部分病人通過根治性手術切除,一般可以徹底治癒。肺腺癌病人發生轉移的位置,在對側的肺組織、縱隔的淋巴結、鎖骨上的淋巴結、頸部的淋巴結等等。肺腺癌中晚期的病人通過手術……
A:浸潤性肺腺癌是常見的一類惡性腫瘤,早期的病人如果能夠早發現、早診斷、早治療,大部分病人通過根治性手術切除都可以治癒,一般不會影響壽命。中期的肺腺癌病人在手術治療的同時,需要配合化療、放療、靶向藥物治療等等,控制腫瘤的生長、發展,防止腫瘤的……
A:肺腺癌晚期的病人症狀會越來越嚴重,去世前會出現呼吸困難、皮膚青紫、胸痛、胸悶、劇烈疼痛,是常見的一些症狀。肺腺癌是很嚴重的惡性腫瘤,早期的肺腺癌病人如果能夠早發現、早診斷、早治療,大部分病人通過根治型的手術切除,一般是可以徹底治癒的。中期……